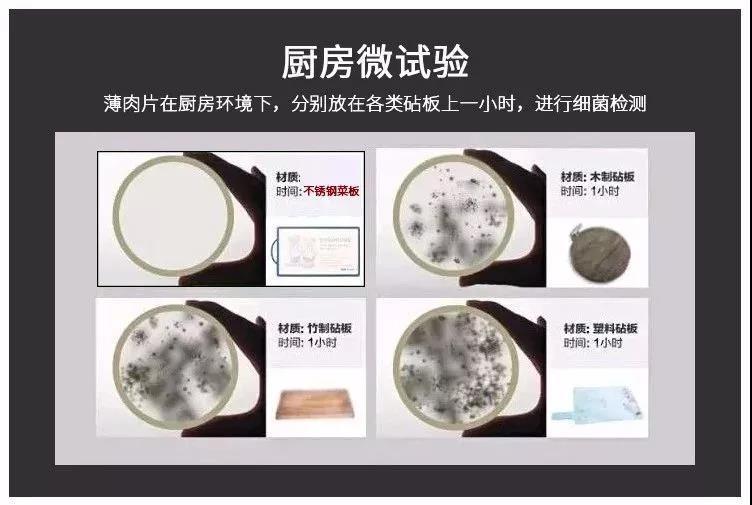
正品不锈钢菜板价格京东,德国双面316不锈钢食品级菜板

每一个厨房中,少不了一样东西,那就是菜板,在上面我们可以任意的改变食物的形状,让食材变得美味可口。要想食物美味必须有一个好的菜板。那么他来了,价格便宜又好用,提前告诉大家今天这款产品不需要任何优惠券,只需要58元即可带回家,性价比贼拉高!

日常生活中,我们最常用的是木质的菜板,我们也会觉得用木头来做菜板是是最好不过的了,但是这么多年使用下来,发现木菜板最容易发霉滋生细菌、掉木屑,而且有时候剁肉或者劲使大了,那种槽就留下来了,影响食材的味道不说,还影响着我们的健康。

德国人跳出了木质菜板束缚框,想到了其他的材质来做菜板,或许有更好的效果。

对于德国而言,最强的就是他们的德国车,奔驰、保时捷、迈巴赫.....都体现着他们的工匠精神。德国人大胆的思维,加上强大工业 制造做支撑,他们的这种精神不仅限于大工业,很多的一些生活用品也是品质满满。他们带着这这种奔驰的精神,来到了厨房中菜板,这次,他们颠覆了传统!不过德国制造确实很厉害!

304不锈钢菜板有着140年的历史的巴本豪森,就用精湛的德国技术,打造出一件件顶级厨具,从设计到工艺,都满足了你对厨房的完美幻想,爱上品质的生活,更爱上健康。顶级厨师用的刀具都是德国制造,锋利而且耐用。

下面我们详细了解这款菜板到底有什么与众不同呢?
① 304不锈钢菜板尽显高品质生活
一套好的厨具,能够使人在做饭的过程中变得愉悦,享受这个过程,还能对食物原味的升华。

巴本豪森选用了食品级304不锈钢作材质,不仅可以与食物直接接触,更具有耐用、耐腐蚀、防霉抗菌、去异味的性能。

不起沫、不掉屑,不出现刀痕,更不会隐藏食物残渣,保留食物的原汁原味。

② 天然金属CU,健康又卫生
这块菜板有天然金属CU,当不锈钢合金与空气、水分子接触发生触媒作用,会释放出铁离子将异味分子结构分解,还原食物本身本身的味道。

最大的好处就是不用担心细菌疯狂滋生的问题,还具有抗菌祛腥的功能。
我们在使用过程中,将肉片分别放置在不锈钢菜板、木质、竹制、塑料的菜板1小时,通过显微镜观察的细菌含量。
可以看到不锈钢菜板上面的细菌是非常的少,而普通菜板的表面则是布满了。

用了它之后切了肉之后,用水冲一下就没有肉腥味了,再去切水果,也不会把肉的腥味串到水果中去。

家里面的那块菜板不知道用了多少年了,爸妈总是舍不得换掉,考虑到他们的健康,这种菜板要赶紧换掉,这也是表现孝心的一种方式。

③ 加厚菜板,可切可斩
它比起几十厘米的普通砧板厚0.2毫米,而且正反面都可以用,十分方便。

不用担心不锈钢案板容易损伤菜刀,食品级304不锈钢比菜刀硬度要低。但是,在上面想切就切,想斩就斩,也不会伤到。

④ 切菜声音不刺耳
经过拉丝抛光等十几项工艺处理后,不锈钢案板的表面更有质感,也更防滑,切山药和肉块也不怕滑溜溜的,不用担心食材滑动不好切。

细节之处也是处理的很到位。边角打磨处理,圆润不伤手。

便携提手设计,使用的时候方便拿取,不使用的时候也刚变挂起来。

相比传统的竹木案板,只需要一冲一抹就干净,不像普通菜板还要拿钢丝球刷使劲的刷,碎渣是干净了,木渣又被刷出来了。

担心切菜的时候声音太大,我们也有做过测试,切硬番茄发出的声音保持在50分贝左右,而我们平时正常说话的声音是在40~60分贝,这个声音是完全能够接受的。

巴本豪森为了满足大家不同的使用需求,定制了四个不同的尺寸,大家可以根据自己的需要选择。家里面人多可以用一个大的,自己一个人在外可以选择一个中号,或者单独备一个用来作为切水果的。

美味而健康的菜,是少不了一个好的菜板。有了它或许就会爱上做饭,爱上自己的厨房。
家里面还是很久之前父母打折十几块钱买的菜板,已经不像样子了,为了他们的健康,就给他们换成这个304不锈钢菜板。我们不在身边陪伴,那就让健康一直陪着父母。
价格不贵,只要58元,也就是一顿外卖的钱。
点击下方横幅的“去看看”就能直接购买了。

器材库 德国304不锈钢砧板 防霉祛腥 健康易清洗 无刺音不伤刀
¥58
购买